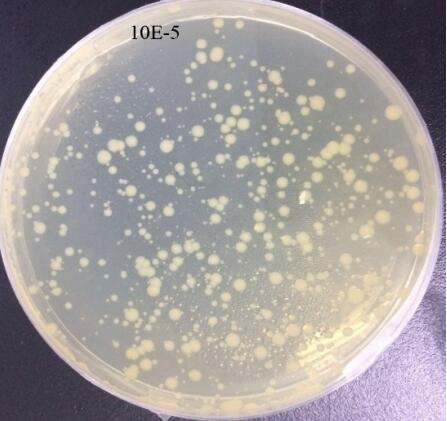
E. coli suspension before high-pressure homogenization
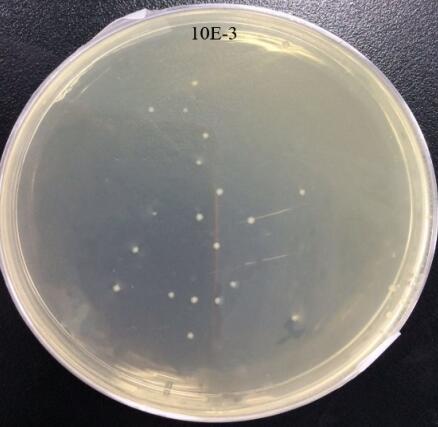
E. coli suspension after 3 passes of high-pressure homogenization
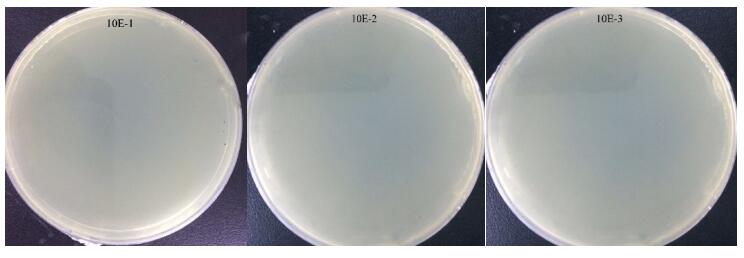
E. coli suspension after 5 passes of high-pressure homogenization

E. coli Cell Disruption by High-Pressure Homogenization
What is E. coli cell disruption and how to disrupt E. coli cells?
Escherichia coli (E.coli) cell disruption is essential in microbial research, protein purification, and biotechnological applications. disruption is essential in microbial research, protein purification, and biotechnological applications. Among the available methods, high-pressure homogenization provides efficient, reproducible, and scalable E. coli cell disruption, making it ideal for laboratory and industrial purposes.How does High-Pressure Homogenization work for E. coli cell disruption?
During high-pressure homogenization, E.coli cells pass through an interaction chamber containing micro-scale channels under high pressure. Intense shear, impact, turbulence, cavitation, and sudden pressure drops lead to cell disruption, rupturing cell walls and membranes and releasing intracellular contents into the solution.
This method, also known as cell lysis, enables efficient and reproducible E.coli cell disruption while preserving protein activity.
Compared with chemical lysis or sonication, high-pressure homogenization provides uniform and reproducible E.coli cell disruption and is particularly suitable for high-density cultures. Typical operating pressures range from 12,000–20,000 psi. More than three passes achieve >99.99% disruption, while five passes generally result in complete lysis and consistent protein extraction.
To evaluate the effectiveness of high-pressure homogenization, the following experiments were conducted.
Experimental Setup for E. coli Cell Disruption
1. Experimental Method
E. coli samples were homogenized 3–5 times using the NanoGenizer-30K high-pressure homogenizer equipped with RT-cooling diamond interaction chambers (H30Z-RT & H10Z-RT) and a heat exchanger. The temperature was maintained at 4 °C using a chilled water bath to preserve protein activity.
2. Disruption Rate Test Method
2.1 Viable Bacteria Counting
After 24 hours of cultivation, the E. coli fermentation broth was centrifuged at 4,000 rpm for 15 minutes, the supernatant was discarded, and the cells were resuspended in buffer. Then, 100 µL of an appropriate dilution was applied to a plate containing ampicillin and chloramphenicol for viable bacteria counting. The remaining bacterial solution was divided into two portions and homogenized at 15,000 psi for 3 passes and 5 passes, respectively. After homogenization, 100 µL of each bacterial solution was taken, appropriately diluted, plated, and the viable bacteria were counted.2.2 Protein Extraction
Bacterial samples were homogenized 3 or 5 times at 15,000 psi using the NanoGenizer-30K. The homogenate was centrifuged at 11,000–13,000 rpm for 15 minutes, and the supernatant was collected for protein extraction and quantification. This process ensures consistent recovery of intracellular proteins.3. Experimental Results
3.1 Appearance after Homogenization
3 passes: solution contained numerous flocculent particles and layering; bacterial fragments relatively large.5 passes: solution more uniform, indicating thorough homogenization.

3.2 Pre-Homogenization Count
Diluted 10³ times: ~500 colonies → estimated concentration 5×10⁸ CFU/mL.
3.3 Post-Homogenization (3 passes)
Diluted 10³ times: ~20 colonies → ~2×10⁴ CFU/mL.
3.4 Post-Homogenization (5 passes)
Diluted 10, 10², and 10³: no colonies observed → 100% cell lysis.
3.5 Protein Extraction
Bacterial proteins were effectively extracted with similar efficiency using Z-type interaction chambers (3 or 5 passes) or Y-type interaction chambers (5 passes).
Conclusion
- 3 passes of high-pressure homogenization achieved >99.99% E. coli cell disruption (lysis).
- 5 passes achieved complete cell disruption.
- Protein extraction yields remained consistent across different passes and chamber types.

Laboratory-Scale High-Pressure Homogenizer – NanoGenizer (up to 45,000 psi)
The NanoGenizer supports precise pressure control, efficient cooling, and reproducible results, making it ideal for microbial cell disruption (including bacteria, yeast, algae, mammalian, and insect cells) and protein extraction. It is also suitable for related applications such as nanoemulsions, fat emulsions, liposomes, nano dispersions, deagglomeration, and lipid nanoparticles, etc.

 USD
USD 949-932-0294 Los Angeles
949-932-0294 Los Angeles  Nano@Genizer.com
Nano@Genizer.com